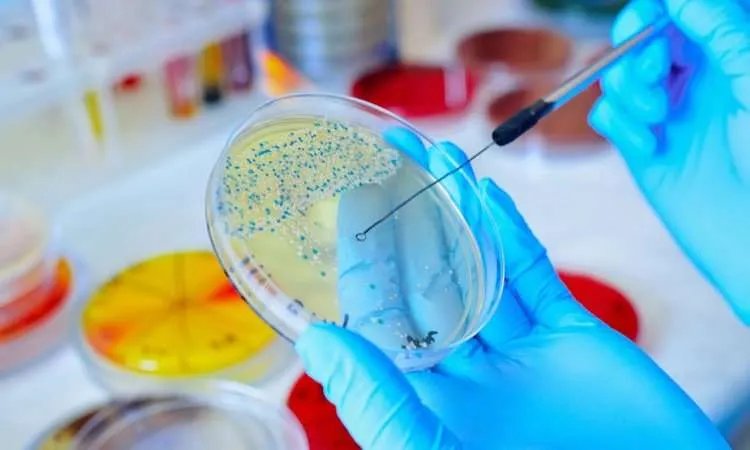

Από τη Γιάννα Τριανταφύλλη.
Στην τελευταία φάση δοκιμών σε ανθρώπους εισέρχεται ένα νέο αντιβιοτικό που θα μπορούσε να σώσει εκατομμύρια ζωές, καθώς έχει αποδειχθεί ότι καταπολεμά το Acinetobacter baumannii, ένα από τα πιο επικίνδυνα και ανθεκτικά στα φάρμακα βακτήρια παγκοσμίως.
Η ελβετική φαρμακευτική εταιρεία Roche ανακοίνωσε χθες ότι προχωρά στο τρίτο και τελευταίο στάδιο των δοκιμών για τη δοκιμή ενός ισχυρού αντιβιοτικού για την αντιμετώπιση ενός κοινού ανθεκτικού βακτηρίου που προκαλεί σοβαρές νοσοκομειακές λοιμώξεις, με κυριότερες την πνευμονία και την σήψη.
Το αντιβιοτικό ζοσουραβαλπίνη, το οποίο αναπτύχθηκε από κοινού με το Πανεπιστήμιο του Χάρβαρντ, κατά την τελική φάση πρόκειται να δοκιμαστεί έναντι του ανθεκτικού στα φάρμακα βακτηρίου acinetobacter baumannii σε περίπου 400 ασθενείς από όλο τον κόσμο.
Η δοκιμή φάσης 3 θα συγκρίνει τις επιδράσεις της ζοσουραβαλπίνης με τις τρέχουσες τυπικές θεραπείες και, εάν είναι επιτυχής, εκτιμάται ότι το φάρμακο θα μπορούσε να είναι έτοιμο για έγκριση στα επόμενα δέκα χρόνια.
«Τα ανθεκτικά στα αντιβιοτικά υπερμικρόβια είναι μια από τις μεγαλύτερες προκλήσεις για τη δημόσια υγεία στις μολυσματικές ασθένειες. Στόχος μας είναι να συνεισφέρουμε νέες καινοτομίες για να ξεπεράσουμε αυτή την αυξανόμενη απειλή», δήλωσε ο Michael Lobritz, παγκόσμιος επικεφαλής μολυσματικών ασθενειών της φαρμακευτικής εταιρείας Roche.
Acinetobacter baumannii, το άτρωτο υπερμικρόβιο
Το Acinetobacter baumannii, που έχει ταξινομηθεί από τον Παγκόσμιο Οργανισμό Υγείας(ΠΟΥ) ως «κρίσιμο παθογόνο προτεραιότητας 1», ανήκει σε μια κατηγορία βακτηρίων που ονομάζονται Gram-αρνητικά βακτήρια και αποτελεί μια σημαντική αιτία μόλυνσης στα νοσοκομεία. Η ανάπτυξη νέων θεραπειών κατά αυτού του βακτηρίου είναι εξαιρετικά δύσκολη, επειδή είναι πολύ ικανό να εμποδίζει τα αντιβιοτικά να διαπεράσουν το εξωτερικό του κυτταρικό στρώμα.
Οι αρχικές κλινικές δοκιμές έδειξαν ότι το φάρμακο ζοσουραβαλπίνηέχει την ικανότητα να διαπερνά την εξωτερική μεμβράνη του βακτηρίου και να σκοτώνει πολλά στελέχη του που μέχρι σήμερα ήταν εξαιρετικά ανθεκτικά στα φάρμακα.
Τα Κέντρα Ελέγχου και Πρόληψης Νοσημάτων (CDC) χαρακτηρίζουν το βακτήριο acinetobacter baumannii ως «επείγουσα απειλή», καθώς τα τελευταία 50 χρόνια δεν έχουν δημιουργηθεί αντιβιοτικά που να το αντιμετωπίζουν αποτελεσματικά. Κάθε χρόνο, οι σοβαρές νοσοκομειακές λοιμώξεις που προκαλεί το ανθεκτικό υπερμικρόβιο, όπως η πνευμονία και η σήψη, οδηγούν στο θάνατο εκατομμύρια ανθρώπους.
Σύμφωνα με στοιχεία του ΠΟΥ, παγκοσμίως, η πνευμονία σκοτώνει τρία έως τέσσερα εκατομμύρια ανθρώπους κάθε χρόνο, με υψηλότερη νοσηρότητα και θνησιμότητα ιδιαίτερα μεταξύ των ηλικιωμένων ασθενών. Εξίσου δυσοίωνα είναι τα στοιχεία και για την σήψη, η οποία εκτιμάται ότι κάθε χρόνο προκαλεί περίπου 11 εκατομμύρια θανάτους , δηλαδή έναν θάνατο κάθε 2,8 δευτερόλεπτα.